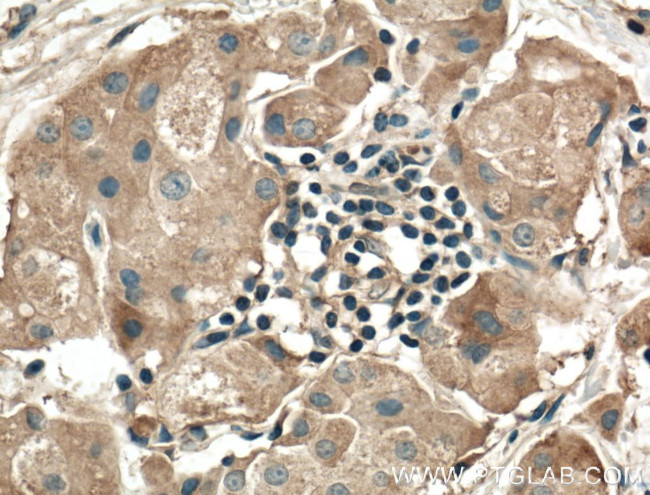
RALA Antibody in Immunohistochemistry (Paraffin) (IHC (P))

Search
Proteintech
RALA Polyclonal Antibody
{{$productOrderCtrl.translations['antibody.pdp.commerceCard.promotion.promotions']}}
{{$productOrderCtrl.translations['antibody.pdp.commerceCard.promotion.viewpromo']}}
{{$productOrderCtrl.translations['antibody.pdp.commerceCard.promotion.promocode']}}: {{promo.promoCode}} {{promo.promoTitle}} {{promo.promoDescription}}. {{$productOrderCtrl.translations['antibody.pdp.commerceCard.promotion.learnmore']}}
产品信息
13629-1-AP
种属反应
已发表种属
宿主/亚型
分类
类型
抗原
偶联物
形式
浓度
规格
纯化类型
保存液
内含物
保存条件
运输条件
产品详细信息
Immunogen sequence: MAANKPKGQ NSLALHKVIM VGSGGVGKSA LTLQFMYDEF VEDYEPTKAD SYRKKVVLDG EEVQIDILDT AGQEDYAAIR DNYFRSGEGF LCVFSITEME SFAATADFRE QILRVKEDEN VPFLLVGNKS DLEDKRQVSV EEAKNRAEQW NVNYVETSAK TRANVDKVFF DLMREIRARK MEDSKEKNGK KKRKSLAKRI RERCCIL (1-206 aa encoded by BC039858)
靶标信息
Multifunctional GTPase involved in a variety of cellular processes including gene expression, cell migration, cell proliferation, oncogenic transformation and membrane trafficking. Accomplishes its multiple functions by interacting with distinct downstream effectors. Acts as a GTP sensor for GTP-dependent exocytosis of dense core vesicles. Plays a role in the early stages of cytokinesis and is required to tether the exocyst to the cytokinetic furrow. The RALA-exocyst complex regulates integrin-dependent membrane raft exocytosis and growth signaling. Key regulator of LPAR1 signaling and competes with GRK2 for binding to LPAR1 thus affecting the signaling properties of the receptor. Required for anchorage-independent proliferation of transformed cells.
仅用于科研。不用于诊断过程。未经明确授权不得转售。
生物信息学
蛋白别名: -ral simian leukemia viral oncogene homolog A (ras related); GTP-binding protein (ral); MGC48949; ral-A protein; RALA Ras like proto-oncogene A; Ras family small GTP binding protein RALA; ras related GTP binding protein A; RAS-like protein A; RAS-like, family 1; Ras-related protein Ral-A; small GTP binding protein; unnamed protein product; v-ral simian leukemia viral oncogene homolog A (ras related)
基因别名: 3010001O15Rik; AW322615; HINCONS; RAL; Ral-a; RALA; Rasl1
UniProt ID: (Human) P11233, (Mouse) P63321, (Rat) P63322
Entrez Gene ID: (Human) 5898, (Mouse) 56044, (Rat) 81757